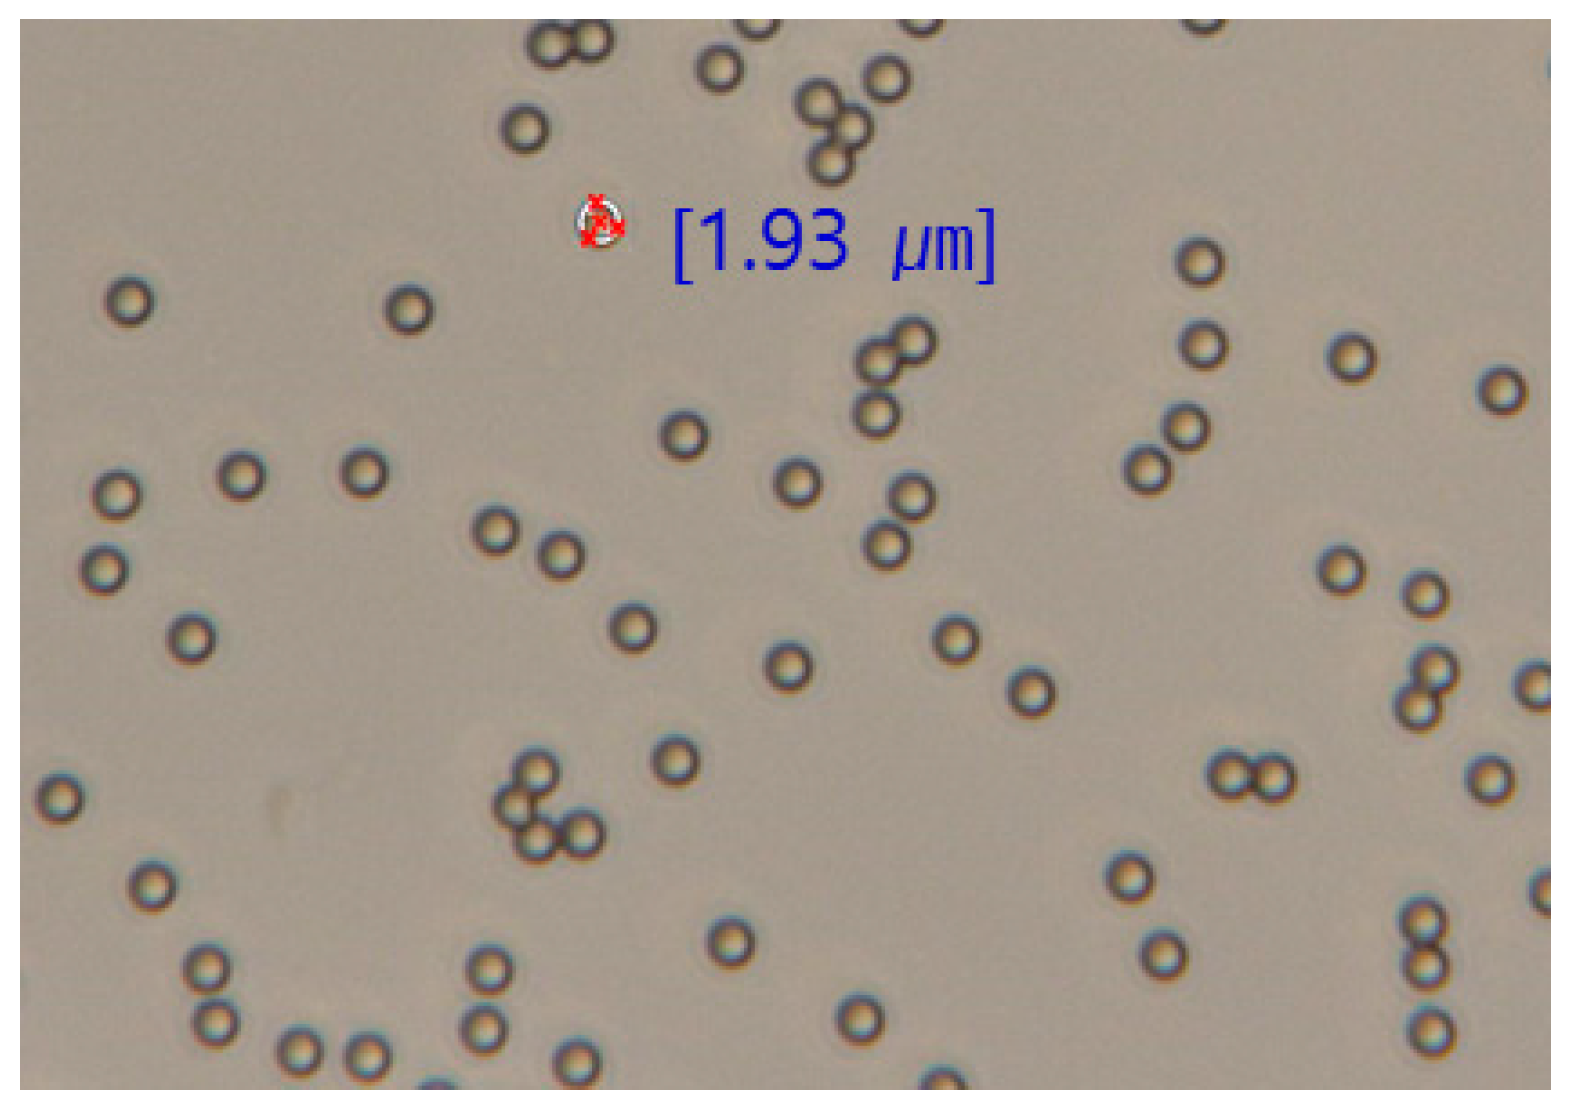
Applsci 11 04328 g002 Applsci 11 04328 g002

A Study on the Flow Characteristics of Copper Heavy Metal Microfluidics with Hydrophobic Coating and pH Change
Abstract
1. Introduction
2. Materials and Methods
2.1. Materials
2.2. Methods
2.2.1. Microfluidic Flow Test
2.2.2. CFD Numerical Analysis
3. Results and Analysis
3.1. Microfluidic Flow Characteristic
3.1.1. pH 4
3.1.2. pH 6
3.1.3. pH 8
3.1.4. pH 10
3.2. Microfluid Flow Moving Distance
3.3. Microparticle Flow Velocity
3.4. CFD Numerical Analysis
4. Conclusions
- (1)
- As a result of microfluidic flow experiments for heavy copper metal contaminants, it was confirmed that the movement of contaminants was small in locations where the influence of hydrophobic properties was large. This means that hydrophobic surfaces can slow down the flow of hydrophilic heavy metal contaminants.
- (2)
- The analysis of the flow rate according to each experimental condition confirmed that the change in flow rate of pH conditions was an influential factor. It was confirmed that the flow rate increased as the pH was more basic, and it was confirmed that the hydrophobic properties slightly decreased under basic conditions.
- (3)
- Numerical analysis was performed by applying the contact angle, which is a hydrophobic characteristic, however, it was difficult to compare and analyze through CFD analysis. Based on the flow rate according to pH as a result of the experiment, the velocity coefficient was proposed through regression analysis. Using the velocity coefficient, it is determined that the flow rate according to pH on a hydrophobic coated surface can be determined.
Author Contributions
Funding
Institutional Review Board Statement
Informed Consent Statement
Data Availability Statement
Acknowledgments
Conflicts of Interest
References
- Foley, J.A.; Ramankutty, N.; Brauman, K.A.; Cassidy, E.S.; Gerber, J.S.; Johnston, M.; Mueller, N.D.; O’Connell, C.; Ray, D.K.; West, P.C.; et al. Solutions for a cultivated planet. Nature 2011, 478, 337–342. [Google Scholar] [CrossRef] [PubMed]
- Xu, J.; Liu, C.; Hsu, P.C.; Zhao, J.; Wu, T.; Tang, J.; Liu, K.; Cui, Y. Remediation of heavy metal contaminated soil by asymmetrical alternating current electrochemistry. Nat. Commun. 2019, 10, 1–8. [Google Scholar] [CrossRef] [PubMed]
- Bo, S.; Luo, J.; An, Q.; Xiao, Z.; Wang, H.; Cai, W.; Zhai, S.; Li, Z. Efficiently se-lective adsorption of Pb(II) with functionalized alginate-based adsorbent inbatch/column systems: Mechanism and application simulation. J. Clean. Prod. 2020, 250, 119585. [Google Scholar] [CrossRef]
- Adriano, D.C.; Wenzel, W.W.; Vangronsveld, J.; Bolan, N.S. Role of assisted natural remediation in environmental cleanup. Geoderma 2004, 112, 121–142. [Google Scholar] [CrossRef]
- Amundson, R.; Berhe, A.A.; Hopmans, J.W.; Olson, C.; Sztein, A.E.; Sparks, D.L. Soil and human security in the 21st century. Science 2015, 348, 1261071. [Google Scholar] [CrossRef] [PubMed]
- Liu, L.; Li, W.; Song, W.; Guo, M. Remediation techniques for heavy metal-contaminated soils: Principles and applicability. Sci. Total Environ. 2018, 633, 206–219. [Google Scholar] [CrossRef] [PubMed]
- Park, K.O. A Study on Soil Washing Efficiency of Copper(Cu) Contaminated Soil in Military Rifle Range Site. Master’s Thesis, Kyungpook National University Graduate School of Industry, Daegu, Korea, 2013. [Google Scholar]
- Chen, R.; Sherbinin, A.D.E.; Ye, C.; Shi, G. China’s soil pollution: Farms on the frontline. Science 2014, 344, 691. [Google Scholar] [CrossRef] [PubMed]
- Yang, H. China’s soil plan needs strong support. Nature 2016, 536, 375. [Google Scholar] [CrossRef] [PubMed]
- Liu, B.L.; Ai, S.W.; Zhang, W.Y.; Huang, D.J.; Zhang, Y.M. Assessment of the bioavailability, bioaccessibility and transfer of heavy metals in the soil-grain-human systems near a mining and smelting area in NW China. Sci. Total Environ. 2017, 609, 52–60. [Google Scholar] [CrossRef] [PubMed]
- Fei, X.F.; Christakos, G.; Xiao, R.; Ren, Z.Q.; Liu, Y.; Lv, X.N. Improved heavy metal mapping and pollution source apportionment in Shanghai City soils using auxiliary information. Sci. Total Environ. 2019, 661, 168–177. [Google Scholar] [CrossRef] [PubMed]
- Rui, D.; Wu, Z.; Ji, M.; Liu, J.; Wang, S.; Ito, Y. Remediation of Cd- and Pbcontaminated clay soils through combined freeze-thaw and soil washing. J. Hazard. Mater. 2019, 369, 87–95. [Google Scholar] [CrossRef] [PubMed]
- Tao, Y.; Huang, H.; Zhang, H. Remediation of Cu-phenanthrene co-contaminated soil by soil washing and subsequent photoelectrochemical process in presence of persulfate. J. Hazard. Mater. 2020, 400, 123111. [Google Scholar] [CrossRef] [PubMed]
- Trellu, C.; Pechaud, Y.; Oturan, N.; Mousset, E.; van Hullebusch, E.D.; Huguenot, D.; Oturan, M.A. Remediation of soils contaminated by hydrophobic organic compounds: How to recover extracting agents from soil washing solutions? J. Hazard. Mater. 2021, 404, 124137. [Google Scholar] [CrossRef] [PubMed]
- Shin, E.C.; Lee, M.S.; Park, J.J. A Study on the Numerical Analysis for Soil Contamination Prediction in Incheon Area. J. Korea Geosynth. Soc. 2012, 11, 21–30. [Google Scholar] [CrossRef]
- Song, B.; Zeng, G.; Gong, J.; Liang, J.; Xu, P.; Liu, Z.; Zhang, Y.; Zhang, C.; Cheng, M.; Liu, Y.; et al. Evaluation methods for assessing effectiveness of in situ remediation of soil and sediment contaminated with organic pollutants and heavy metals. Environ. Int. 2017, 105, 43–55. [Google Scholar] [CrossRef] [PubMed]
- Kjeldsen, P.; Barlaz, M.A.; Rooker, A.P.; Baun, A.; Ledin, A.; Christensen, T.H. Present and long-term composition of MSW landfill leachate: A review. Crit. Rev. Environ. Sci. Technol. 2002, 32, 297–336. [Google Scholar] [CrossRef]
- Han, W.J.; Fu, F.L.; Cheng, Z.H.; Tang, B.; Wu, S.J. Studies on the optimum conditions using acid-washed zero-valent iron/aluminum mixtures in permeable reactive barriers for the removal of different heavy metal ions from wastewater. J. Hazard. Mater. 2016, 302, 437–446. [Google Scholar] [CrossRef] [PubMed]
- Han, Z.Y.; Ma, H.N.; Shi, G.Z.; He, L.; Wei, L.Y.; Shi, Q.Q. A review of groundwater contamination near municipal solid waste landfill sites in China. Sci. Total Environ. 2016, 569, 1255–1264. [Google Scholar] [CrossRef] [PubMed]
- You, J.H. Bio-Molecula Separation Using Nano Porous Membrane On-Chip. Master’s Thesis, Seoul National University Graduate School, Seoul, Korea, 2009. [Google Scholar]
- Kim, N.H. Fabrication and characterization of porous membrane foe high precision gas filter by in-situ reduction/sintering process. Ph.D. Thesis, Hanyang University, Seoul, Korea, 2010. [Google Scholar]
- Ministry of Environment. White Paper of Environment 2018; Ministry of Environment: Sejong-si, Korea, 2018.

| Classification | Test Condition | |||
|---|---|---|---|---|
| Pollutants | Concentration (ppm) | Flow Velocity (cm/s) | pH | |
| Flow characteristic of pollutants | Copper | 6000 | 1.0 × 10−3 | 4, 6, 8, 10 |
| Flow Rate (cm/s) | Contract Angle | |||
|---|---|---|---|---|
| pH 4 | pH 6 | pH 8 | pH 10 | |
| 1.0 × 10−3 | 124° | 125° | 119° | 116° |
| pH | ||||
|---|---|---|---|---|
| 4 | 6 | 8 | 10 | |
| Flow rate (cm/s) | 1.272 × 10−3 | 1.272 × 10−3 | 1.272 × 10−3 | 1.264 × 10−3 |
Publisher’s Note: MDPI stays neutral with regard to jurisdictional claims in published maps and institutional affiliations. |
© 2021 by the authors. Licensee MDPI, Basel, Switzerland. This article is an open access article distributed under the terms and conditions of the Creative Commons Attribution (CC BY) license (https://creativecommons.org/licenses/by/4.0/).
Share and Cite
Han, J.-G.; Jung, D.; Lee, J.-Y.; Kim, D.; Hong, G. A Study on the Flow Characteristics of Copper Heavy Metal Microfluidics with Hydrophobic Coating and pH Change. Appl. Sci. 2021, 11, 4328. https://doi.org/10.3390/app11104328
Han J-G, Jung D, Lee J-Y, Kim D, Hong G. A Study on the Flow Characteristics of Copper Heavy Metal Microfluidics with Hydrophobic Coating and pH Change. Applied Sciences. 2021; 11(10):4328. https://doi.org/10.3390/app11104328
Chicago/Turabian StyleHan, Jung-Geun, Dongho Jung, Jong-Young Lee, Dongchan Kim, and Gigwon Hong. 2021. "A Study on the Flow Characteristics of Copper Heavy Metal Microfluidics with Hydrophobic Coating and pH Change" Applied Sciences 11, no. 10: 4328. https://doi.org/10.3390/app11104328
APA StyleHan, J.-G., Jung, D., Lee, J.-Y., Kim, D., & Hong, G. (2021). A Study on the Flow Characteristics of Copper Heavy Metal Microfluidics with Hydrophobic Coating and pH Change. Applied Sciences, 11(10), 4328. https://doi.org/10.3390/app11104328

